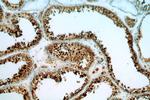
BAG1 Antibody in Immunohistochemistry (Paraffin) (IHC (P))

Search
Proteintech
BAG1 Polyclonal Antibody
{{$productOrderCtrl.translations['antibody.pdp.commerceCard.promotion.promotions']}}
{{$productOrderCtrl.translations['antibody.pdp.commerceCard.promotion.viewpromo']}}
{{$productOrderCtrl.translations['antibody.pdp.commerceCard.promotion.promocode']}}: {{promo.promoCode}} {{promo.promoTitle}} {{promo.promoDescription}}. {{$productOrderCtrl.translations['antibody.pdp.commerceCard.promotion.learnmore']}}
产品信息
19064-1-AP
种属反应
宿主/亚型
分类
类型
抗原
偶联物
形式
浓度
规格
纯化类型
保存液
内含物
保存条件
运输条件
产品详细信息
This antibody can recognize all the isoforms of BAG1.
Immunogen sequence: PAQRGPPPS RRPPARSTAS GHDRPTRGAA AGARRPRMKK KTRRRSTRSE ELTRSEELTL SEEATWSEEA TQSEEATQGE EMNRSQEVTR DEESTRSEEV TREEMAAAGL TVTVTHSNEK HDLHVTSQQG SSEPVVQDLA QVVEEVIGVP QSFQKLIFKG KSLKEMETPL SALGIQDGCR VMLIGKKNSP QEEVELKKLK HLEKSVEKIA DQLEELNKEL TGIQQGFLPK DLQAEALCKL DRRVKATIEQ FMKILEEIDT LILPENFKDS RLKRKGLVKK VQAFLAECDT VEQNICQETE RLQSTNFALA E (36-345 aa encoded by BC014774)
靶标信息
The oncogene BCL2 is a membrane protein that blocks a step in a pathway leading to apoptosis or programmed cell death. The protein encoded by this gene binds to BCL2 and is referred to as BCL2-associated athanogene. It enhances the anti-apoptotic effects of BCL2 and represents a link between growth factor receptors and anti-apoptotic mechanisms. At least three protein isoforms are encoded by this mRNA through the use of a non-AUG (CUG) start site, and alternative, downstream, AUG translation initiation sites.
仅用于科研。不用于诊断过程。未经明确授权不得转售。
生物信息学
蛋白别名: BAG family molecular chaperone regulator 1; BAG-1; BAG-1L; Bcl-2 associating athanogene-1 protein; Bcl-2-associated athanogene 1; Bcl-2-binding protein; BCL2 associated athanogene 1; BCL2-associated athanogene; glucocortoid receptor-associated protein RAP46; receptor-associated protein, 46-KD; RP11-326F20.2
基因别名: BAG-1; BAG1; HAP; RAP46
UniProt ID: (Human) Q99933, (Mouse) Q60739, (Rat) B0K019
Entrez Gene ID: (Human) 573, (Mouse) 12017, (Rat) 297994